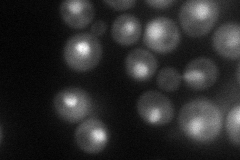
YPL016W
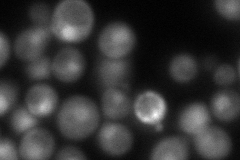
YPL016W
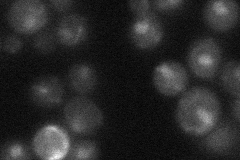
YPL016W
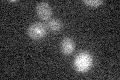
YPL016W

View description
Subunit of the SWI/SNF chromatin remodeling complex, which regulates transcription by remodeling chromosomes; required for transcription of many genes, including ADH1, ADH2, GAL1, HO, INO1 and SUC2; can form the prion [SWI+]
Localization:
Intensity:
Fold change:
Significance:
-
C’ GFP library in SD

below threshold14.54 -
N' NOP1pr-GFP in SD
nucleus67.136 -
N' TEF2pr-mCherry in SD
cytosol,nucleus15.6602 -
N' NATIVEpr-GFP in SD
punctate,nucleus23.3969 -
N' TEF2pr-VC and Cyto-VN in SD

below threshold23.0325 -
C’ GFP library in SD+DTT

cytosol16.221.11No -
C’ GFP library in SD+H2O2

cytosol17.631.21No -
C’ GFP library in Starvation Media
cytosol16.31.12No -
C’ GFP library on the background of Pup2-DaMP

below threshold -
C’ GFP library on the background of CCT mutant

below threshold17.46461.20035No
